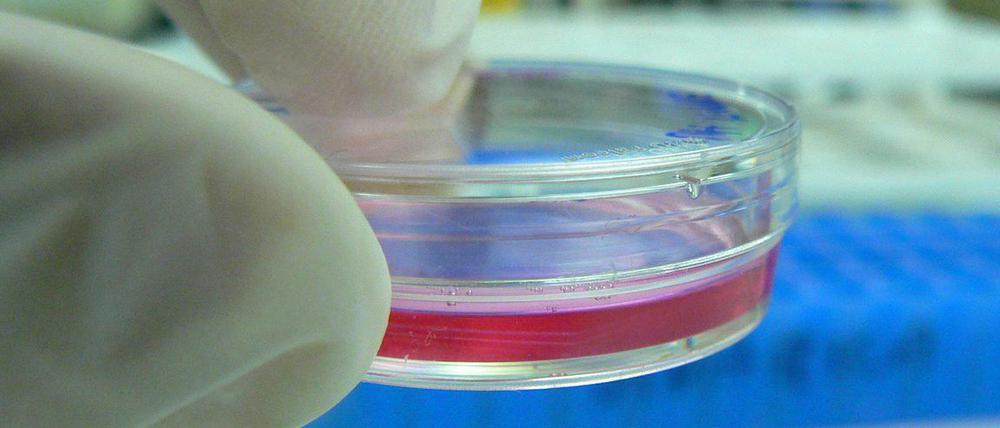

© J. Wu/Stanford
Tumortherapie: Impfung mit Stammzellen hemmt Krebs
Stammzellen ähneln ein Stück weit Krebszellen und können offenbar als Impfstoff das Immunsystem von Mäusen gegen Tumore wappnen.
Stand:
Mit speziellen Stammzellen haben Forscher Mäuse vor einer späteren Tumorerkrankung geschützt. Sie hatten im Labor Körperzellen der Mäuse in Stammzellen rückverwandelt – genannt iPS-Zellen (induzierte pluripotente Stammzellen). Diese ähneln ein Stück weit Krebszellen, können sich etwa ebenfalls unbegrenzt vermehren. Wurden Mäuse mit solchen abgetöteten iPS-Zellen geimpft, löste das bei den Tieren Immunreaktionen gegen die Zellen aus. Transplantierten die Forscher später Tumore, ging das Immunsystem der Mäuse gegen die Krebszellen erfolgreicher vor als die Körperabwehr von Tieren, denen keine iPS-Zellen gespritzt worden waren, schreiben die Mediziner im Fachblatt „Cell Stem Cell“.
Zellen könnten als patientenspezifischer Impfstoff dienen
„Wenn sich unsere Ergebnisse auf den Menschen übertragen lassen, könnten iPS-Zellen eines Tages tatsächlich als patientenspezifischer Krebsimpfstoff dienen“, sagte Joseph Wu von der Stanford University, Leiter des Forscherteams.
Das Prinzip einer Immuntherapie gegen Krebs besteht im Allgemeinen darin, eine gezielt gegen die Tumorzellen gerichtete Immunabwehr auszulösen oder zu verstärken. Um dieses Ziel zu erreichen, untersuchte Wus Team bei Mäusen, ob sich iPS-Zellen als Impfstoff eignen. Eine vorherige Bestrahlung der iPS-Zellen hinderte diese daran, sich im Körper der geimpften Maus zu vermehren.
Geimpfte Mäuse konnten transplantierte Tumore schrumpfen
Viermal im Abstand von jeweils einer Woche wurden den Mäusen die aus ihren eigenen Körperzellen erzeugten – und damit genetisch identischen – iPS-Zellen injiziert. Dann verpflanzten die Mediziner Brustkrebszellen in diese und in unbehandelte Tiere. Nach einer Woche hatten sich in allen Fällen Tumore entwickelt. Diese vergrößerten sich in der Kontrollgruppe immer weiter, während sie bei 70 Prozent der geimpften Mäuse schrumpften. Bei zwei von zehn Tieren verschwand der Tumor völlig und kam auch nach einem Jahr nicht zurück. Ähnliche Ergebnisse ergaben sich bei der Transplantation von Lungen- oder Hautkrebszellen. Offenbar beruht der Effekt auf den T-Zellen des Immunsystems. Als die Forscher T-Zellen von geimpften Tieren auf nicht geimpfte übertrugen, erlangten diese ebenfalls die Fähigkeit, das Wachstum von Krebs zu hemmen. (wsa)
- showPaywall:
- false
- isSubscriber:
- false
- isPaid: